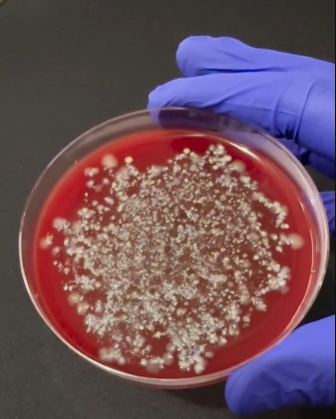
Сколько микробов на суши. Ученый показал то, что трудно "развидеть" (видео)

Сколько микробов на суши. Ученый показал то, что трудно "развидеть" (видео)
Безопасно ли есть суши (фото: freepik.com)
Известный микробиолог Бруно Брунетти показал, сколько микробов может быть на роллах и суши с рыбой. Любимое блюдо многих, как оказалось, отнюдь не безопасно, поэтому следует проявлять максимальную бдительность.
Об этом сообщает РБК-Украина (проект Styler) со ссылкой на видео, которое микробиолог разместил на своей странице в Instagram.
Сколько микробов на еде - это трудно "развидеть"
Микробиолог решил показать, что суши с рисом и сырой рыбой могут быть настоящим рассадником для бактерий. Сначала ученый сделал посев бактерий и перенес специальный контейнер в автоклав. Затем он продемонстрировал, что там "выросло".

Сколько микробов на суши (скриншоты)
Увиденное впечатляет. На суши было много микробов. По словам ученого, они могли попасть на еду из-за нескольких факторов.
Первый - грязные руки повара. Если человек, готовящий суши, не соблюдает основные правила гигиены и санитарные требования, вероятность того, что он "заразит" блюдо микробами, такими как фекальная палочка, очень высока.
Второй фактор - грязная кухня. Посуда, инструменты и все поверхности, где готовят и хранят суши, а также ингредиенты этого блюда, должны быть чистыми. Но не все заведения питания соблюдают эти правила.
Третий фактор - качество продуктов. Иногда предприниматели хотят сэкономить на основном и готовы потерять качество. Поэтому они покупают плохие продукты, которые неправильно хранились или вообще не имеют сертификатов качества.
"И чтобы было понятно, я никого не призываю прекращать есть суши! Это просто предупреждение о рисках загрязнения такого типа пищи... Ведь каждый знает кого-то, кто плохо провел время после поедания суши, правда?" - объяснил ученый.
Раньше мы уже рассказывали, чем на самом деле ужинают балерины.
Кроме того, недавно стало известно, что в Украину завезли чай, который вызывает судороги, паралич и смерть.